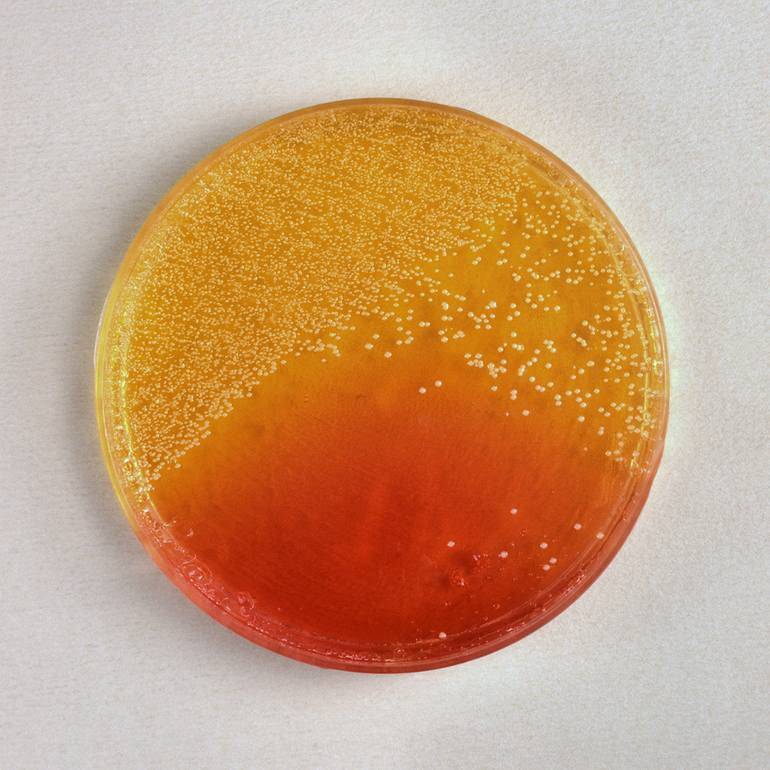
View in a Room Artwork

85 Views
1
View In My Room
Mario Mutschlechner
Mexico
Photography, Color on Paper
Size: 16.5 W x 16.5 H x 0.1 D in
Ships in a Tube
85 Views
1
Artist featured in a collection
In the early eighties I photographed at the Medical Center of Mexico City petri dishes with bacterial colonies as covers for the magazine "Infectología" published by the Mexican Association of Infectology. Their diversity, color and beauty motivated me in 2020 to publish a few samples with their sc...
1981
Photography, Color on Paper
Limited Edition of 5
16.5 W x 16.5 H x 0.1 D in
Not Applicable
Not Framed
Certificate is Included
Ships Rolled in a Tube
Shipping is included in price.
Typically 5-7 business days for domestic shipments, 10-14 business days for international shipments.
The purchase of photography and limited edition artworks as shipped by the artist is final sale.
Ships rolled in a tube. Artists are responsible for packaging and adhering to Saatchi Art’s packaging guidelines.
Mexico.
Shipments from Mexico may experience delays due to country's regulations for exporting valuable artworks.
Need more information?
Need more information?
As a retired industrial photographer from Cologne, Germany, based since 1967 in Mexico City, I used my craft for decades to document scenes and subjects in sharp, detailed and well lit images. Back in the seventies, when simulating views of other planets, I was looking for a different perception of reality and found it with infrared color film. Today I enjoy a creative freedom similar to that of a painter. With the right combination of photograph and digital manipulation I can create images that are a tribute to imagination and beauty. Starting in 2019 I present on Saatchiart 16 collections as a synopsis of my photography, some digitally remastered and others digitally modified, for sale as archival inkjet prints in different sizes.
Artist featured by Saatchi Art in a collection
We deliver world-class customer service to all of our art buyers.
Explore an unparalleled artwork selection from around the world.
Our 14-day satisfaction guarantee allows you to buy with confidence.
We pay our artists more on every sale than other galleries.
